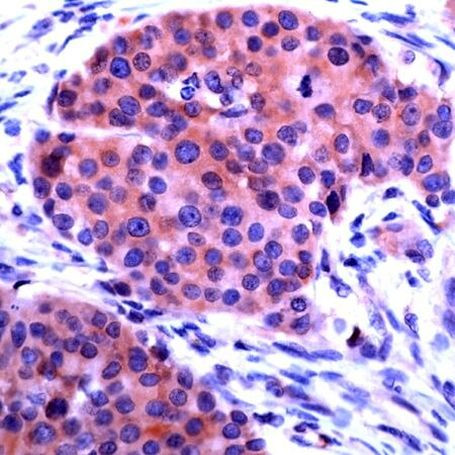
CHOP Antibody in Immunohistochemistry (IHC)

Search
Invitrogen
CHOP Polyclonal Antibody
{{$productOrderCtrl.translations['antibody.pdp.commerceCard.promotion.promotions']}}
{{$productOrderCtrl.translations['antibody.pdp.commerceCard.promotion.viewpromo']}}
{{$productOrderCtrl.translations['antibody.pdp.commerceCard.promotion.promocode']}}: {{promo.promoCode}} {{promo.promoTitle}} {{promo.promoDescription}}. {{$productOrderCtrl.translations['antibody.pdp.commerceCard.promotion.learnmore']}}

Please note: We are reviewing Western blot images included in the antibody testing data in our catalog, including those provided by third parties. Unless expressly labeled or annotated as “raw-unedited”, Western blot images included in the antibody testing data in our catalog may have been edited, optimized or otherwise adjusted for presentation.
产品信息
PA5-32419
宿主/亚型
分类
类型
抗原
偶联物
形式
保存条件
运输条件
产品详细信息
Heat-mediated antigen retrieval is recommended prior to staining, using a 10mM citrate buffer, pH 6.0, for 10 minutes followed by cooling at room temperature for 20 min. Following antigen retrieval, incubate samples with primary antibody for 10 min at room temperature. A suggested positive control is breast carcinoma.
靶标信息
GADD153 is a small nuclear protein that is capable of dimerizing with transcription factors C/EBP alpha and beta. Once dimerized, this complex inhibits the normal binding and function of C/EBP to classical binding sites. Inversely, the C/EBP GADD153 dimer gains binding activity to other non classical C/EBP stress related targets. Under normal cellular conditions this protein is not expressed in detectable levels, but is highly unregulated during times of cellular/ER stress. Examples of GADD153 inducing stress include: treatment with tunicamycin, nutrient starvation and reducing agents that interfere with the calcium flux across the ER membrane.
仅用于科研。不用于诊断过程。未经明确授权不得转售。